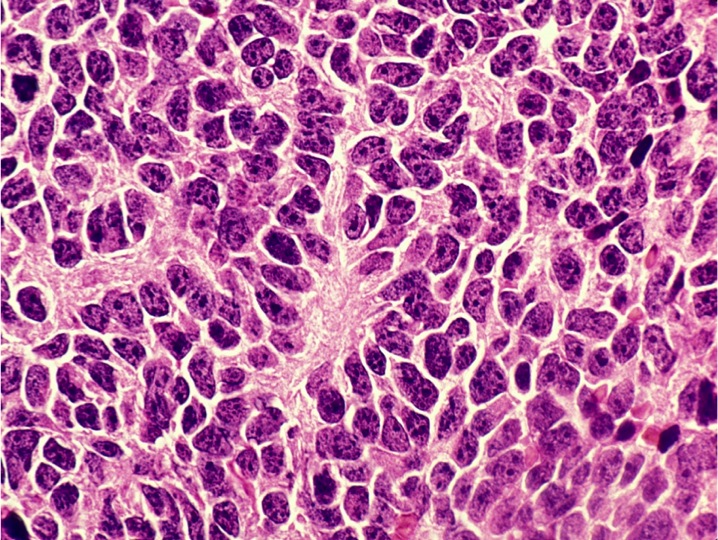
Trovata una nuova cura contro il medulloblastoma

Il medulloblastoma è il più diffuso tumore cerebrale dell’infanzia e, nonostante l’accettabile tasso di sopravvivenza, la tossicità dei trattamenti oggi in uso, in particolare la radioterapia, lasciano nei pazienti danni gravi, tra cui disturbi cognitivi permanenti e neoplasie secondarie. Un gruppo di ricercatori dell’Istituto di biologia cellulare e neurobiologia del Consiglio nazionale delle ricerche (Ibcn-Cnr) di Roma mettendo a profitto l’esperienza derivata da un decennio di studi sullo sviluppo dei neuroni nel cervello e nel cervelletto (neurogenesi), ha dimostrato in vivo che dopo il trattamento con la proteina Cxcl3, anche se il tumore ha già iniziato a svilupparsi, il medulloblastoma non si forma più o scompare completamente. Lo studio è pubblicato su Frontiers in Pharmacology.
“Già nel 2012 avevamo identificato la chemokina Cxcl3 quale possibile target terapeutico, dimostrando che la mancanza di questa proteina si lega a un notevole aumento della frequenza del medulloblastoma, poiché i precursori cerebellari, cioè le cellule giovani che poi diventano neuroni, non riescono più a migrare al di fuori della zona proliferativa alla superficie del cervelletto e tendono a diventare neoplastici. Una permanenza eccessiva nella zona proliferativa rende cioè i precursori più suscettibili alle mutazioni che inducono la proliferazione incontrollata”, spiega Felice Tirone dell’Ibcn-Cnr, che ha guidato la ricerca in collaborazione con Manuela Ceccarelli e Laura Micheli.“Utilizzando questa informazione, abbiamo ora dimostrato che se un modello murino che sviluppa medulloblastoma con alta frequenza viene trattato per un mese per via intracerebellare con Cxcl3, a due mesi da quando il tumore ha già iniziato a svilupparsi, il medulloblastoma non si forma più o scompare completamente”.
La peculiarità di questo studio è la procedura totalmente diversa da quelle in uso, che si basano sul blocco della proliferazione dei precursori cerebellari neoplastici mediante sostanze tossiche. “Il nostro approccio sfrutta invece la plasticità residua del precursore cerebellare neoplastico, in quanto Cxcl3 ne forza la migrazione al di fuori della zona proliferativa del cervelletto verso la parte interna, dove i precursori neoplastici differenziano, uscendo definitivamente dal programma di sviluppo del tumore”, precisa il ricercatore.
Si sta ora studiando l’applicabilità nell’uomo di questo trattamento, che è stato brevettato dal Cnr (Cxcl3 chemokine for the therapeutic treatment of medulloblastoma, Patent WO 2014053999 A1). “Cxcl3 sembra essere privo di tossicità anche ad alte dosi, ma resta da chiarire se la plasticità dei precursori cerebellari tumorali, cioè la capacità di differenziare dopo la migrazione, permane a stadi più avanzati del tumore”, conclude Tirone. “Un’applicazione possibile sarebbe nella sindrome di Gorlin, dove il medulloblastoma è trasmesso geneticamente (frequenza 1:50.000), e quindi la sua insorgenza è più prevedibile e monitorabile sin dalle fasi iniziali di sviluppo”.
Questa ricerca è stata finanziata con una borsa di studio della Fondazione italiana per la ricerca sul cancro assegnata a Manuela Ceccarelli nel 2014 e dal progetto Fare Bio del Ministero dello sviluppo economico assegnato a Felice Tirone.